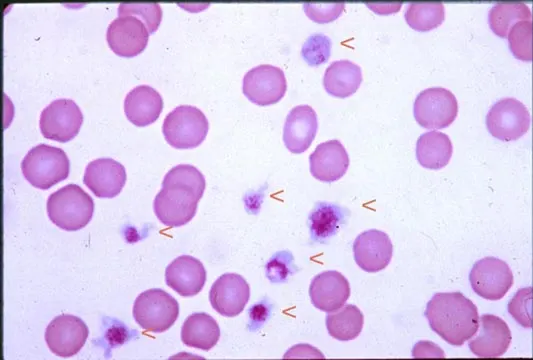
Featured Image
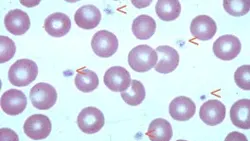
Featured Image

Evaluating the Bleeding Patient: Point-of-Care Tests
Marjory Brooks, DVM, Diplomate ACVIM, Comparative Coagulation Section, Animal Health Diagnostic Laboratory, Ithaca, New York

Hemorrhage is a common chief complaint that prompts veterinary attention. Although the cause of hemorrhage is often apparent from physical examination alone, some cases require diagnostic testing to help differentiate blood loss due to a breach in blood vessel integrity from a systemic failure of normal hemostatic processes. Bleeding diatheses are broadly classified as defects of platelet plug formation (primary hemostasis) or fibrin clot formation (secondary hemostasis).
While there is no single "global" test for hemostasis, simple point-of-care tests can be done to detect the primary and secondary hemostatic defects often encountered in clinical practice. Estimation of platelet count from a stained blood smear readily identifies thrombocytopenia, the most common canine and feline hemostatic abnormality. The ACT is a screening test of the intrinsic and common coagulation pathways, and a prolonged ACT is found in most patients with clinically significant coagulation factor deficiencies. The BMBT is an in vivo test of primary hemostasis that can aid in identifying patients with severe platelet dysfunction and severe von Willebrand's disease. The following discussion describes the procedures for performing these screening tests.
ACT = activated clotting time; BMBT = buccal mucosa bleeding time; CBC = complete blood count; DIC = disseminated intravascular coagulation; EDTA = ethylenediaminetetraacetate; OIF = oil immersion field
Point-of-Care Tests for Hemostasis
Platelet Estimate from Blood Smear
Activated Clotting Time
Buccal Mucosa Bleeding Time
Step-by-Step: How to Test for Hemostasis
Platelet Estimate from Blood Smear
What You Will Need
Whole blood collected in anticoagulant. EDTA blood samples drawn for CBC are typically used.
Clean glass slides
Cytology stain (eg, Wright's stain, Diff-Quik)
Step 1
Avoid platelet activation during blood collection and processing by careful venipuncture: draw blood directly into a tube or syringe containing anticoagulant, gently mix the sample, maintain the sample at room temperature, and prepare the smear as soon as possible after blood collection.
Step 2
Prepare and stain the blood smear.
Procedure Pearl
Carefully examine the feathered edge of the smear to detect platelet clumping, the most common cause of spurious low platelet counts and inaccurate platelet estimate.

Stained smear

EDTA blood sample and unstained smear
Step 3
Examine the feathered end of the smear at low magnification to detect platelet clumping that would result in an inaccurate estimation of the platelet count.
Step 4
Examine the smear under oil immersion (1000×), scanning fields with red cells distributed in a single layer.
Step 5
Determine the average number of platelets in 10 OIFs.
Step 6
Estimate platelet count using the following formula:
average # platelets/OIF × 15,000 = platelets/µl
Test Interpretation & Additional Diagnostic Evaluation
Although mild thrombocytopenia develops in many disease syndromes, clinical signs of abnormal hemostasis are typically seen in patients with platelet counts below 50,000/µl. The finding of low platelet numbers from the initial slide estimate should be followed with a CBC, including platelet count, and additional tests to differentiate platelet production defects, sequestration or consumption defects, or immune-mediated platelet destruction. These tests can include bone marrow examination, splenic aspiration cytology, serologic evaluation to detect infectious agents, coagulation testing to define a DIC process, and measurement of platelet-bound antibody.
Procedure Pearl
The finding of at least 10 to 12 platelets per OIF indicates a normal platelet count.
Arrowheads indicate platelets. Note the range in platelet size (100× objective).
Arrowheads indicate platelets (100× objective)
Activated Clotting Time One-Tube Technique*
What You Will Need
21- or 22-gauge needle
ACT sample tube (evacuated tube containing a particulate activator)
37º C heating block or water bath
Timer or stopwatch

Procedure Pearl
Blood collection from peripheral veins is preferable, if patient size allows, to minimize risk for hematoma formation at the jugular vein.
Step 1
Warm the ACT tube to 37ºC for 1 minute before sampling.
Step 2
Perform venipuncture and collect blood directly into the ACT tube.
Procedure Pearl
The ACT can be measured using automated instruments that warm the sample and then detect and display the time for clot formation in a reaction cuvette.

Close-up of blood in the ACT tube immediately after collection. Note that the blood is freely flowing and therefore evenly dispersed in the tilted tube.
Step 3
Allow the tube to completely fill by vacuum.
Step 4
Immediately after the blood is drawn, gently tilt the tube several times to mix the blood with the activator and start the timer.
Step 5
Place the tube in a 37ºC heating block or water bath.
Step 6
After a 45-second incubation time, gently tilt the tube at 10-second intervals to detect clot formation.
Step 7
The ACT is the time elapsed from blood collection to clot formation.
Step 8
Expected ACT for dogs is less than 120 seconds; for cats less than 165 seconds.
Test Interpretation & Additional Diagnostic Evaluation
ACT is prolonged in the following conditions: deficiency of one or more coagulation factors in the intrinsic and common pathways, fibrinogen deficiency, and heparin anticoagulant effect. Specific coagulopathies that prolong ACT include anticoagulant rodenticide toxicity, severe liver disease, hemorrhagic DIC, and such hereditary factor deficiencies as hemophilia A (Factor VIII deficiency), hemophilia B (Factor IX deficiency), and Factor XII deficiency. The finding of prolonged ACT should be followed with a full coagulation panel (activated partial thromboplastin time, prothrombin time, fibrinogen assay) and specific factor analyses if needed for a definitive diagnosis.
Procedure Pearl
An ACT reference range should be established in-house for the manual or instrument method in use.

Close-up of formation of a fibrin clot in the ACT tube. The clot protrudes into the tube lumen when the tube is tilted.
Procedure Pearl
The ACT is influenced by nonspecific variables (such as platelet count, incubation temperature, blood viscosity, hematocrit) in addition to prolongation caused by coagulation factor deficiencies and anticoagulant therapy.
Buccal Mucosa Bleeding Time
What You Will Need
Muzzle gauze
Stopwatch or timer
Bleeding time template device (Surgicutt-ITC, Edison, NJ; Simplate-Organon Teknika, Durham, NC)
Filter paper or gauze sponge

Step 1
Position the patient in sternal or lateral recumbency.
Step 2
Evert the upper lip and use a strip of gauze wrapped snugly around the muzzle to secure the lip in place.

The dog’s upper lip has been snugly secured with muzzle gauze in preparation for the BMBT test.
Step 3
Position the template device on the exposed buccal mucosa.
Procedure Pearl
The BMBT should be performed only on patients with normal platelet count, since thrombocytopenia can prolong BMBT regardless of platelet function.
Step 4
Simultaneously trigger the device to incise the mucosa and start a timer.

Close-up of the fine blades that produce a standarddepth incision after the device has been triggered
Step 5
Blood flows freely from the BMBT wounds immediately after incision. Gently blot underneath the incision with filter paper or gauze to collect blood flowing from the wound. Do not wipe or directly touch the wound.

Filter paper or gauze is placed below (not directly on) the wound to collect blood. The time from triggering the device until blood flow ceases is the BMBT.
Step 6
The BMBT is the time from triggering the device until cessation of blood flow.

Blood flows freely from the BMBT wounds immediately after incision.
Step 7
After completion of the test, remove the gauze and apply direct pressure to the wounds. If needed, tissue glue can be applied to prevent rebleeding.
Step 8
The expected BMBT for dogs is less than 4 minutes.
Procedure Pearls
Although the incision causes only momentary discomfort, it is easier to perform and monitor the test if the patient is sedated or anesthetized.
The BMBT is prolonged in patients with severe platelet dysfunction and severe von Willebrand's disease; however, other variables, such as hematocrit, platelet count, and operator technique, can influence the test.
Test Interpretation & Additional Diagnostic Tests
Mild to moderate platelet dysfunction occurs in many common diseases and secondary to drug therapy; therefore, initial follow-up should include complete history and general medical evaluation. Marked prolongation of BMBT (> 12 minutes) in patients with normal platelet count is compatible with a lack of von Willebrand's factor or failure of platelet aggregation. Definitive diagnosis of these conditions is based on specific measurement of plasma von Willebrand's factor concentration or platelet aggregation testing.
Procedure Pearl
The BMBT has proven to be a poor predictor of surgical hemostasis when used as a routine preoperative screening test in human patients.